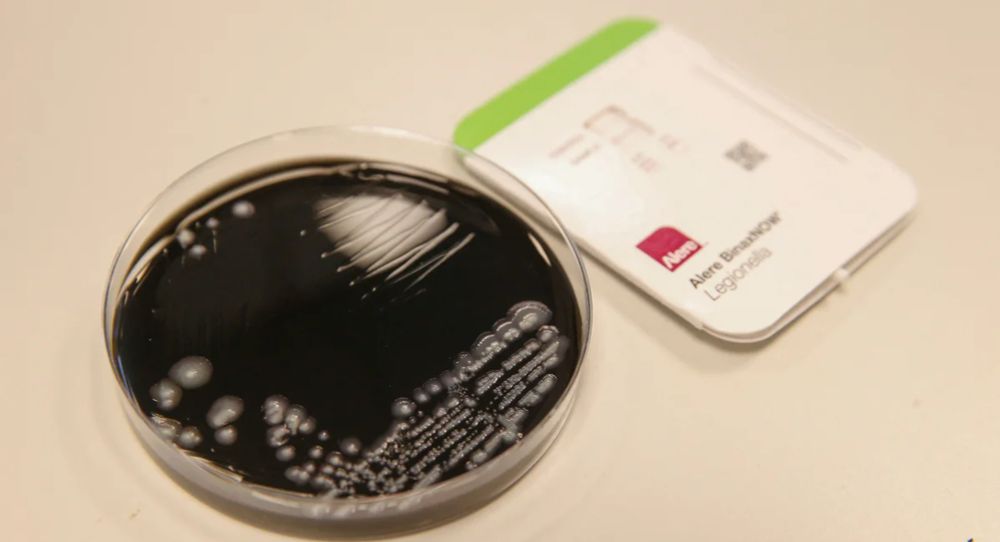

It’s important to pay for local journalism but not like this.
www.thecity.nyc/2025/08/20/w...
@joehong.bsky.social
Investigative data reporter for WNYC and Gothamist http://joehong.work

It’s important to pay for local journalism but not like this.
www.thecity.nyc/2025/08/20/w...
The current outbreak of Legionnaires' disease in NYC has sickened 73 people and killed three. In the first six months of this year, the city conducted a historically low number of inspections designed to prevent such outbreaks. new for @wnyc.org/@gothamist.com
gothamist.com/news/legionn...

A lot of the districts that went to Trump and then to Mamdani are in Asian American neighborhoods. The "Asian American voter" is a fraught demographic, but it makes sense as to why some of these immigrant communities supported two such radically different candidates.
gothamist.com/news/why-man...

Mamdani came out on top in about a third of the NYC districts that Trump won last year. How did the progressive candidate win over votes in these districts? Check out this team effort for @wnyc.org / @gothamist.com, featuring a map of the primary/election results--
gothamist.com/news/how-vot...

After spending the entire primary season criticizing the former governor, Democratic mayoral candidate Jessica Ramos announced today that she'd be endorsing Andrew Cuomo, signaling a sudden split from a progressive coalition. Her now former allies aren't too happy.
gothamist.com/news/andrew-...

The rate of car crashes across NYC are dropping more quickly since the start of congestion pricing. The number of injuries is nearly back down to the historic, pandemic-era lows. My latest for @gothamist.com and @wnyc.org
gothamist.com/news/nyc-car...

The story of how one neighborhood went from being a gun-violence hot spot to outpacing the rest of the city in reducing gun violence. From Brittany Kriegstein for @gothamist.com / @wnyc.org
gothamist.com/news/how-com...

Deaths among NYers experiencing homelessness were down in 2024. Death rates for sheltered residents were also much, much lower than for non-sheltered individuals. But the city's biggest win was with preventing overdoses. My latest for @gothamist.com and @wnyc.org
gothamist.com/news/drug-re...

An amazing example of public service data journalism from @sophlebo.bsky.social and Michael Cahana of @nyc.streetsblog.org -- nyc.streetsblog.org/2025/04/16/m...
16.04.2025 13:57 — 👍 1 🔁 1 💬 0 📌 0
The effort to close Rikers Island has been a decade-long marathon for NYC. But the delays in shuttering the jail has resulted in loud, late-night sprints to finish construction on Brooklyn's borough-based jail. My latest for @wnyc.org/@gothamist.com
gothamist.com/news/the-noi...

Nearly 4-in-10 New York City residents are immigrants, according to the latest profile of immigration in the five boroughs.
04.04.2025 20:19 — 👍 10 🔁 4 💬 0 📌 1
The deep cuts to the U.S. Department of Education has stalled critical investigations into discrimination at NYC's public schools. From @jessicagould.bsky.social
gothamist.com/news/civil-r...

Eric Adams announced on Thursday morning that he'll run for re-election as an independent. He said the recently dismissed corruption case had hindered his ability to launch an effective campaign for the Democratic primary in June. Follow @gothamist.com for updates
gothamist.com/news/mayor-e...
New York Attorney General Letitia James and a coalition of her counterparts from other states have asked a federal judge to block some $11 billion in cuts to public health initiatives ordered by the Trump administration.
01.04.2025 14:58 — 👍 12 🔁 4 💬 1 📌 0
The search continues for the owner of a dog rescued from the East River yesterday. In the meantime, the shelter has renamed the pup "Hudson." My first piece for @gothamist.com
gothamist.com/news/recogni...

To defeat Andrew Cuomo, NYC’s progressive candidates may need to form strategic coalitions. Ranked-choice voting could help them level the playing field. The latest from my @gothamist.com colleague Liz Kim: gothamist.com/news/mayor-c...
28.03.2025 13:58 — 👍 3 🔁 0 💬 0 📌 0
An old NYPD stationhouse in Brownsville has been sitting empty for around 40(!) yrs
Now a developer is tearing it down and building a 100% affordable apartment complex
The project was made possible today when NYCHA agreed to transfer air rights and a sliver of land
gothamist.com/news/brookly...
This is my first week as an investigative data reporter for @wnyc.org and @gothamist.com! Send me all nyc-related tips and story ideas--
email: jhong@nyc.org
proton mail: joe@joehong.work
signal: jhong.01

Absenteeism among Native American students increased the most in NM during the pandemic, according to data compiled in 34 states by @asssociatedpress.bsky.social. The response has included everything from more events at schools to tribal leaders making home visits www.chalkbeat.org/2024/12/03/n...
03.12.2024 15:54 — 👍 1 🔁 4 💬 0 📌 0
Facing legal threats, colleges back off race-based programs
As might be expected of someone working toward a Ph.D. in neuroscience at Stanford School of Medicine, Jocelyn Ricard has impressive credentials. There are scholarships — Knight-Hennessy and, last year, a Ford Foundation Fellowship — and…
Thank you Christina!
23.11.2024 14:00 — 👍 0 🔁 0 💬 0 📌 0
Latest from me for @hechingerreport.org and Wisconsin Public Radio:
The past, present and future of math in Milwaukee Public Schools: can the district recreate its golden era?
In the 2023-24 school year, I'll be working on a series of stories about the past, present and future of math education! I'd love to connect with math education folks on Blue Sky!
My DMs are open. Professional website coming soon!